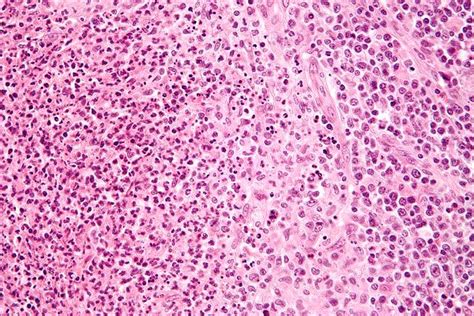
Mikroskopické zobrazenie baktérií

Hnedý výtok: Pochopenie Príčin a Súvislostí s Duphastonom
Hnedý výtok u žien môže byť znepokojujúci, no často ide o bežný jav s rôznymi príčinami. Pochopenie jeho podstaty, najmä v kontexte užívania liekov ako Duphaston, je kľúčové pre správnu interpretáciu a prípadné riešenie. Tento článok sa zameriava na rozličné aspekty hnedého výtoku, od jeho fyziologických príčin až po potenciálne zdravotné problémy, a osvetľuje jeho súvislosť s liečbou Duphastonom.
Hnedý výtok počas menštruácie a po nej
Menštruácia sa nemusí dostaviť hneď v plnej sile, často sa ohlasuje výtokom, ktorý je svetlo až tmavo hnedej farby. Podobne sa menštruácia prejavuje v posledných dňoch periódy. Keď je tok krvi z maternice pomalší, krv oxiduje, čo spôsobuje jej hnedé zafarbenie. Tento proces je prirodzený a súvisí s pomalším odtokom krvi z maternice, ktorá sa tak stihne okysličiť. Hnedý výtok na začiatku alebo konci menštruácie je teda zvyčajne normálnym javom a nie je dôvodom na obavy.

Hnedý výtok v priebehu cyklu a hormonálna nerovnováha
Pokiaľ sa objaví slabší výtok približne dva týždne pred menštruáciou a skoro odznie, môže to mať súvis s ovuláciou. Tento jav, známy ako ovulačné špinenie, je spôsobený poklesom hladiny estrogénu po ovulácii, čo môže viesť k miernemu uvoľneniu sliznice maternice.
Hnedý výtok v priebehu cyklu môže znamenať hormonálnu nerovnováhu. Tá nastáva v prípade, kedy je hladina estrogénu nižšia, ako je potrebné ku stabilizácii sliznice v maternici. Táto sa následne môže začať uvoľňovať a následkom toho môže spôsobovať špinenie, alebo nepravidelné krvácanie. Hormonálna nerovnováha je častou príčinou nepravidelného krvácania a špinenia mimo menštruačného cyklu.
K slabšiemu krvácaniu, alebo hnedému výtoku mimo menštruácie niekedy dochádza aj počas prvých mesiacov užívania hormonálnej antikoncepcie. Telo si na nové hormóny postupne zvyká a tieto krátkodobé zmeny sú často normálnou reakciou.
Duphaston a hnedý výtok: Skúsenosti a otázky
Užívanie lieku Duphaston, ktorý obsahuje syntetický progesterón, je často predpisované na stabilizáciu menštruačného cyklu, liečbu nepravidelnej menštruácie, alebo ako podpora v tehotenstve. V kontexte užívania Duphastonu sa môže objaviť aj hnedý výtok, čo vyvoláva otázky u pacientok.
Jedna z používateliek sa podelila o svoju skúsenosť: "Ahojte. Už druhý mesiac užívam Duphaston, od 15. dňa cyklu 10 dní… Mám vraj polycystické vaječníky a nepravidelnú menštruáciu… Mám 18 a som panna, tehotná nie som…. Prvý mesiac mi menštruácia prišla na 29. deň… Tak som myslela, že mi pomohol… No tento mesiac som na 29. deň dostala taký hnedý výtok, ktorý trvá už 6 dní… Je ho ale málo… Menštruácia mi mešká už siedmy deň.. Prosím má niekto podobnú skúsenosť? Dostanem ešte menštruáciu či nie? Okrem Duphastonu užívam ešte výživový doplnok Inofolic."
Táto skúsenosť poukazuje na to, že aj napriek užívaniu Duphastonu sa môže objaviť hnedý výtok, ktorý sa líši od očakávanej menštruácie. V tomto prípade môže hnedý výtok signalizovať, že liečba má vplyv na cyklus, ale nie vždy priamo vyvolá plnohodnotnú menštruáciu v očakávanom termíne. Kombinácia Duphastonu s doplnkami ako Inofolic, ktoré tiež ovplyvňujú hormonálnu rovnováhu, môže viesť k komplexnejším reakciám organizmu.
⚕️Vysvetlenie dydrogesterónu (Duphaston): Použitie, dávkovanie, bezpečnosť a ďalšie!
Hnedý výtok v tehotenstve a Duphaston
V tehotenstve môže byť hnedý výtok tiež zdrojom obáv. Jedna používateľka uvádza: "Dobry den chcem sa spytat som tehotna cca 6tt mala som slaby hnedy vytok, lekarka mi predpisala duphaston ale len na 10 dni a na kontrolu mam ist az za dva tyždne. Je to normalne? Citala som ze to moze vyvolat potrat ked sa prestane brat. Lebo sa potom znizi ten hormon."
V tomto prípade lekár predpísal Duphaston na podporu tehotenstva a stabilizáciu sliznice maternice, čo je bežná prax pri hroziacom potrate alebo pri špinení v skorom štádiu tehotenstva. Obavy z vysadenia lieku sú pochopiteľné, nakoľko progesterón hrá kľúčovú úlohu v udržaní tehotenstva. Dĺžka liečby a načasovanie kontrolnej návštevy závisia od individuálneho stavu pacientky a rozhodnutia lekára. Je dôležité dodržiavať pokyny lekára a neprerušiť liečbu bez jeho konzultácie.
Iné potenciálne príčiny hnedého výtoku
Hoci hnedý výtok väčšinou nemá závažnú príčinu, sú aj prípady, kedy sa takto manifestuje gynekologické ochorenie. Z toho dôvodu je dobré sledovať prípadné ďalšie prejavy a v prípade pochybností sa obrátiť na lekára.
Polycystické vaječníky (PCOS): Toto ochorenie sa najčastejšie objavuje u žien v produktívnom veku. Základným problémom, ktorý túto chorobu spôsobuje, je nerovnováha ženských a mužských pohlavných hormónov v prospech pôsobenia mužských hormónov. Medzi prejavy tohoto ochorenia patrí úplne chýbajúca, alebo veľmi obmedzená ovulácia, cysty na vaječníkoch, rozvoj cukrovky, prejavy nadmerného ochlpenia, alebo naopak plešatenia a v neposlednom rade aj hnedý výtok, alebo špinenie.

Endometrióza: Častým ochorením žien v reprodukčnom veku je endometrióza. Bunky sliznice maternice sa nachádzajú aj mimo maternicu, avšak reagujú na hladiny pohlavných hormónov počas menštruácie, následkom čoho dochádza ku krvácaniu a rozvoju zápalu. Toto ochorenie môže sprevádzať bolesť v podbrušku, bolestivá menštruácia a pohlavný styk. Hnedý výtok alebo špinenie môže byť jedným z prejavov endometriózy, najmä ak sa vyskytuje mimo menštruačného cyklu.
Infekcie: Opakované nálezy baktérií vo vaginálnom výtere, ako sú Klebsiella pneumoniae, Proteus mirabilis, Enterococcus faecalis, E.coli, môžu signalizovať infekciu. Napriek liečbe vaginálnymi globulami a masťou sa môžu objavovať nové nálezy. Infekcie môžu spôsobiť zmeny v pošvovej mikroflóre a viesť k neobvyklému výtoku, vrátane hnedého.
Tehotenstvo: Tehotenstvo je od samého začiatku plné telesných premien a neočakávaných prejavov, z ktorých niektoré môžu ženu vystrašiť. Pokiaľ sa v tomto období objaví špinenie, alebo hnedý výtok, nemusí to nutne znamenať niečo zlé. Pokiaľ sa však výtok začne meniť na krvácanie a je sprevádzaný bolesťou v podbrušku, je nevyhnutné okamžite vyhľadať lekára.
Osobné hygienické návyky a hnedý výtok
Pri výtoku, alebo špinení je dôležité dbať na osobnú hygienu. Postačí umytie intímnych partií 2x denne špeciálnym prípravkom GYNELLA® Intimate Wash, ktorý svojim zložením udržiava rovnováhu pošvového prostredia. Alternatívou je GYNELLA® Intimate Foam, jemná umývacia pena, ktorú možno používať aj na holenie intímnych partií. Tieto produkty pomáhajú udržiavať zdravé pošvové prostredie a zmierňovať prípadný zápach alebo nepohodlie.
Zbavuje zápachu a nepohodlia! Jemné mydlo s pumpičkou, ktoré zmierňuje zápach, svrbenie a pálenie. Dbám na dobrú hygienu!
Dôležitosť lekárskej konzultácie
Napriek tomu, že hnedý výtok väčšinou nemá závažnú príčinu, sú aj prípady, kedy sa takto manifestuje gynekologické ochorenie. Z toho dôvodu je dobré sledovať prípadné ďalšie prejavy a v prípade pochybností sa obrátiť na lekára. Lekár je jediný, kto môže stanoviť presnú diagnózu a odporučiť vhodnú liečbu. V prípade akýchkoľvek nejasností alebo pretrvávajúcich problémov s výtokom je vždy najlepším riešením konzultácia s gynekológom.

tags: #duphaston #a #hnedy #vytok
